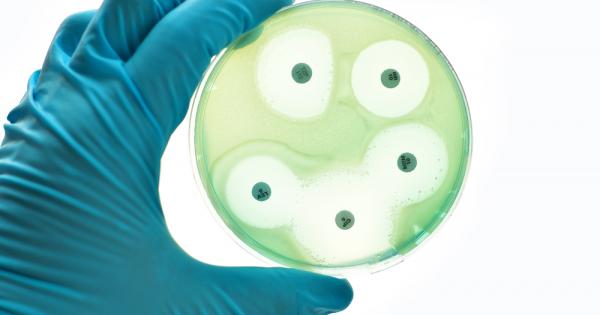
Често се гледа на антибиотичната резистентност като на бъдещ проблем

... издания и е добре познато лице на аудиторията. Другото е възможност за „ново женско присъствие“, като кастингът се очаква да приключи до края на есента.
Тази Водеща - Новини
Не отне много време на неудовлетвореността на Аарон Буун с
...... дори когато шефът на екипажа Джордан Бейкър пристъпи между двойката и продължи да се разбърква, за да блокира пътя на Буун към Томас. Разгледайте повече
Забрана за използването на мобилни телефони в училищата въвежда Финландия
...... за основното образование, приета през април, забранява използването на мобилни телефони от ученици на възраст между 7 и 16 години по време на учебните занятия.
Стопкадър бТВНова водеща имаше Тази сутрин днес Това е парламентарният репортер на бТВ Ванина
...... нови предизвикателства в професионалния си път.Ако има нещо сигурно за Ванина Недкова, това е, че на този етап близкото й бъдеще ще остане свързано с бТВ.
Венета Райкова се пусна в мрежата като ученичка от втори
...... 7 клас я приеха в друго. В нашето училище е учил и Евгений Бакърджиев, както и някои спортисти на „Левски“, сподели Венета Райкова. Инфо: Клюкибг
Малкото симпатично момиченце което виждате на снимката по горе едва ли
...... да се излъчва от понеделник до петък от 09:30 часа.
if DIR hasOwnProperty sectionId DIR sectionId includes 136 Hide ads
...... "); if ( DIR.hasOwnProperty("sectionId") && DIR.sectionId.includes(136) ) { // Hide ads when get PR ZONE document.getElementById("native-wrap-1712677954281").style.display = "none"; } } Как оценявате вашата 2024 година?
Водещата на Преди обед по bTV Оля Малинова разказа че
...... колегите си. Тя добави, че и в самолета е имало и още нещо, което е смятано за български навик - пътниците ръкопляскали, когато самолета кацнал.
Тръгнаха слухове кой ще заеме мястото на Деси Стоянова като водеща
...... добри водещи, но едната има по сериозно поведение, а при другата ще има жълт вкус. За този часови пояс и публика първата беше по-удачен вариант".
Непобедим просто ненадминат на любовния фронт е Благой Георгиев и
...... пола. Както си другарувате, така ще ти го забие, че ще се чудиш откъде ти е дошло", смеят се запалянковци и потребители в мрежата. Източник: Crimesbg.com
На 22 юни събота от 10 ч под купола на
...... огромно значение. Накрая на събитието всички ще имат възможност да си направят снимки с любимата си инфлуенсърка Йоана Йокко. Входът е свободен! Oрганизаторите са подготвил
На 22 юни събота от 10 ч под купола на
...... Повече за Месеца на сколиозата можете да научите тук: https://siz.bg/mesets-na-skoliozata/.* Илюстрацията на плаката е на Теодора Митева, която също преминава лечение на гръбначно изкривяване.
Цънцарова не може да си прочете текста Сконфузна ситуация в
...... че има земетресение“, оплака се синоптичката, докато Цънцарова се оплака: „Всички се смеят, но се смеят тихичко, докато аз не мога да си прочета текста
Личният лекар на Лия Чарлз Кинг диагностицира депресия и я постави
...... имате нужда от спешна помощ, можете да се свържете безплатно със Самаряни на телефон 116 123; имейл: [email protected]; или visitsamaritans.org, за да намерите най-близкия клон.
Давина Маккол 56 се включи в драмата около Ekin Su
...... Домакините от Чешир LEVI ROOTS ВЪЗРАСТ: 65ИЗВЕСТЕН С: Една от най-големите успешни истории на Dragons's Den.НИКИТА КУЗМИН ВЪЗРАСТ: 26ИЗВЕСТЕН С: Да си професионалист в Strictly Come Dancing
Новата водеща на Тази сутрин Кет Дийли е една заета
...... [на SM:TV на живо], така че възможността да работим заедно е наистина забавна“, каза Бен. Следвайте Mirror Celebs на , , , , и .
Водещата на Тази сутрин Сиян Уелби потвърди че баща й
...... работата, тъй като не може да се ангажира с три дни.Казаха се също, че Кристин Лампард не е запалена да работи четири дни в седмицата.
Джейми Лий Къртис се нуждае от предупреждение за да може
...... продължи тя. "Защото копнежът за внимание и признателност за работата ти е универсален. Не ме интересува каква работа вършиш, надяваш се някой да те оцени."
Алисън Хамънд отхвърли огромно увеличение на заплатата за да замени
...... напускането на Холи са се понижили расте, като през ноември и декември се наблюдават най-високите рейтинги за 2023 г., като пиковата аудитория надхвърля един милион.
Моли Кинг имаше поразителна прилика с Холи Уилоуби докато гостува
...... работен ден. Имате естествена химия и това е необходимото, а не принудително. @thismorning знаеш, че има смисъл и ще те върне отново на върха!... '
След като вчера стана ясно че Ромина Тасевска е новата
...... Искам да благодаря и на хората, които цял ден разчистваха уличката, на съседа, който ми подаде ток, в такива моменти хората си помагаме“, разказа Блажев./show.blitz.bg
Аз съм съвсем от скоро в България От 10 дни
...... Белград, Загреб, наистина историята ми е много свързана с Централна и Източна Европа. Горд съм, че посредством тези култури преоткрих нашия континент и неговата идентичност.
Любимият на Цветанка Ризова има афинитет към хубавата музика От
...... да заживее под един покрив с Недев, тв звездата имаше дълга връзка с 12 години по-млад от нея лекар, с когото се разделиха без явна причина.
Димитър Нойков отскоро работи за Worner Bros Discovery като директор
...... – с 10 години по-голям."Той е всичко. Завинаги. Благодарим на нашите кумове. Мария и Милен Керемедчиеви P. S. Приятели, спокойно, купонът тепърва предстои!", написа тя.
От около месец новинарката излиза със заможен бизнесмен който е
...... красавицата се залюби с бившия спортен министър от ГЕРБ – Красен Кралев. Двамата бяха заедно 6 години, но в крайна сметка миналото лято се разделиха.
Разводът на Жени Марчева беше потвърден преди две години Жени
...... никакви бижута по ръцете си, а сега вече носи и пръстен, и халка. Явно има причина за тази промяна и тя най-вероятно е нов брак.
На същото място през 2021 година тя и избраникът й
...... като причина за бързото й завръщане на родна земя Нора посочи, че се е чувствала леко притеснена, оставяйки ги за първи път след раждането сами.
27 годишната репортерка която детронира Жени Марчева и Диана Любенова от
...... филиал на БНР. После пристигнала в София и досущ като в приказката за Пепеляшка се сдобила с приказен живот – богат мъж и завидна кариера.
Новата водеща на Тази събота и неделя Бесте Сабри се
...... филиал на БНР. После пристигнала в София и досущ като в приказката за Пепеляшка се сдобила с приказен живот - богат мъж и завидна кариера.
Дали от медията са решили да разнообразят ефира или смяната
...... Бях взела много заеми, за да плащам лекарства. Случи се най-голямата трагедия в живота ми, загубих Иван.. “, каза в подкаста на Тото Александра. Източник: marica.bg
Това заяви пред Нова телевизия ген Съби Събев първият
...... се свърже тази триада на сухопътните, военноморските и военновъздушните сили на НАТО”, категоричен е Васил Данов, капитан I ранг о.з от Атлантическия съвет на България.
Фермата стартира довечера с нови правила и нова водеща която
...... както земеделци, които не се страхуват да си изцапат ръцете, така актьор, режисьор, балерина, експерт в борбата с финансовите измами, софтуерен инженер и Мис България.
Наскоро една от най популярните ни съвременни тв водещи пусна любопитен
...... в „На кафе“ по Нова телевизия на 9 октомври 2000 г. Шоуто спира да се излъчва в края на юли 2005-та, но се връща на екран на 16 февруари 2009-та, продължава и до днес./show.blitz.bg
Всички се питат какво ще се случи с предаването на
...... посветен на бесленските булки – сватбен ритуал с къна и рисувана гелина, както и за промените в живота на жената в селото след брака. Източник: Уикенд
Малкото симпатично момиченце което виждате на снимката по горе едва ли
...... да се излъчва от понеделник до петък от 09:30 часа.
Една от знаковите журналистки на bTV водещата на съботното сутрешно
...... събота“. В bTV планирали сериозни програмни промени, както и промени на лицата на телевизията за подобряването на рейтинга, който през миналия сезон не бе особено устойчив.
През годините полагаше неимоверни усилия да се втали и да
...... Лора тежеше около 70 кг., а в най-добрите си периоди – 60 кг. Към днешна дата обаче тези килограми са истински мираж за нея. Източник: Уикенд
Би Ти Ви реши да премести предаването на блондинката не
...... чиято водеща е Алекс Сърчаджиева. Най-вероятно причината за това е излизането на екипа в лятна ваканция, а шоуто ще се завърне на екран от есента.
Близо десетилетие е на екран За последните 10 години Нана
...... информацията, че поетапно коронната водеща на "Съдебен спор" ще се оттегли, но няма да е рязко, а постепенно. Най-вероятно докато Тасева бъде приета от зрителите напълно.
След като стана майка Ева Веселинова се посвети изцяло на
...... да се насочи кариерно, след като майчинството ѝ приключи. Бившата тв водеща сподели, че възнамерява да се завърне към журналистиката, което е и нейното призвание.
Често се гледа на антибиотичната резистентност като на бъдещ проблем
...... на антимикробната резистентност, има някои ограничения за тяхното моделиране. Но изводът е ясен: имаме голям глобален здравен проблем. Изследването е публикувано в The Lancet. Източник: Science Alert
Златимир Йочев май вече няма да води сам сутрешния блок
...... тя работеше със Светльо Иванов в „120 минути”. На партито на Би Ти Ви двамата показаха топли колегиални отношения. Нищо чудно отново да заработят заедно.
Гледаме я всеки ден по телевизията Тя е сред най одумваните
...... някой, който да се влюби в теб. Спри да чакаш #щастието и се наслади на сегашния момент. Всеки миг е безценен и уникален", съветва хубавицата.
Водещата на БНТ Мира Добрева винаги е била красива жена
...... бях", пише водещата, цитирана от fakti.bg.Е, всички знаем, че спомените топлят, но носят и носталгия по отминалите времена, когато бяхме млади, безгрижни и много харесвани.
Зверски ми е смешно – така коментира снимката си от
...... спомних и аз каква бях Е, всички знаем, че спомените топлят, но носят и носталгия по отминалите времена, когато бяхме млади, безгрижни и много харесвани.
Любимата ми учителка от ученическите години е г жа Панчева учителката
...... гордее цял Плевен. Забавлявахме се, разхождахме се...", допълни водещата на "На кафе". Тя пожела на всички да имат страст и желание да научават нови неща.
Новата водеща на Тази сутрин май вече е набелязана Кореспондентката
...... че търсят нови кадри, но сутрешният блок е замислен за двама водещи и според източници на “Уикенд” неофициално се провежда кастинг за наследница на Гавазова.
Новата водеща на Тази сутрин май вече е набелязана Кореспондентката
...... че търсят нови кадри, но сутрешният блок е замислен за двама водещи и според източници на “Уикенд” неофициално се провежда кастинг за наследница на Гавазова.
Новата водеща на Тази сутрин май вече е набелязана Кореспондентката
...... си. Към момента не е известно да се е развела, така че съпругът й вероятно също ще се върне у нас заедно със своето семейство.
Любимка на зрителите се връща на работа в bTV Полина
...... Паласт” в Берлин – Александра Георгиева, , Ейми Лий от „Евънесънс“, Тиесто, Армин ван Бюрен и Хардуел, Найджъл Кенеди, Имани, Франк МакКомб и много други.


















:max_bytes(150000):strip_icc():focal(749x0:751x2)/jamie-lee-curtis-oscars-nominee-luncheon-021423-1-2e4504345f21448d96ce4cd23db8e161.jpg)